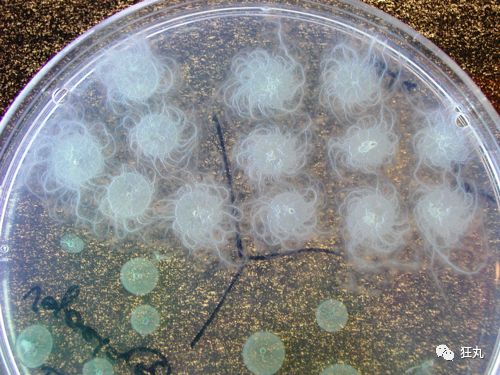
别人家的细菌能画画看着就想舔一口
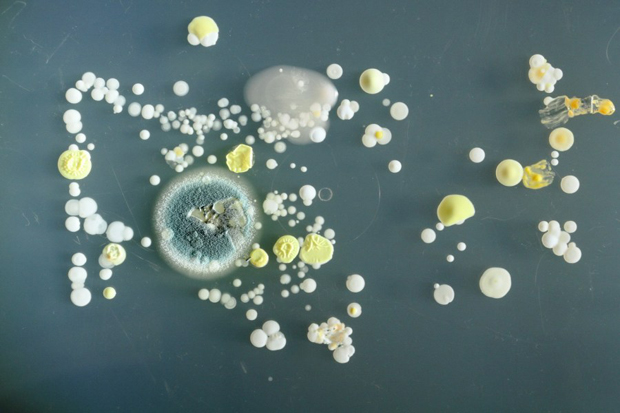
在手机上发现的另一种有害细菌是蕈状芽孢杆菌.

蕈状芽孢杆菌

蕈状芽孢杆菌
图片尺寸364x213
芽孢杆菌
图片尺寸1200x784
蕈状菌,呈棕色,鳃露出来
图片尺寸1200x798
蕈状芽孢杆菌根状生长的图片
图片尺寸4160x2336
梭状芽孢杆菌
图片尺寸1080x810
发明授权cn102796690b 一种蕈状芽孢杆菌及其在促进中国枫香生长中的
图片尺寸1479x1475
蕈状芽胞杆菌: 蕈状芽胞杆菌——营养琼脂48h菌落: 蕈状芽胞杆菌
图片尺寸893x541
英河流中发现"太空细菌" 有望成世界新能源(图)
图片尺寸440x309
别人家的细菌能画画看着就想舔一口
图片尺寸500x375
芽孢杆菌/炭疽芽孢杆菌/巨大芽孢杆菌/蕈状芽孢杆菌/苏云金芽孢杆菌
图片尺寸606x349
蜡状芽孢杆菌蕈状变种
图片尺寸268x201
三天后他们发现了上述的很多种细菌,外加一种特别可怕的蕈状杆菌
图片尺寸800x450
萨里大学学生发现的另一种细菌是蕈状芽孢杆菌.
图片尺寸634x356
蕈状菌,呈棕色,鳃露出来
图片尺寸874x1200
芽孢杆菌,巨大芽孢杆菌,氨化细菌,硝化细菌,硫化还原菌,蕈状芽孢杆菌
图片尺寸250x376
在手机上发现的另一种有害细菌是蕈状芽孢杆菌.
图片尺寸620x413
可致败血病
图片尺寸592x326
你的手机有多脏 细数那些手机上的细菌
图片尺寸308x528
蕈状是什么样子图片_蕈字读qin
图片尺寸1080x719
萨里大学学生发现的另一种细菌是 蕈状芽孢杆菌.
图片尺寸440x247